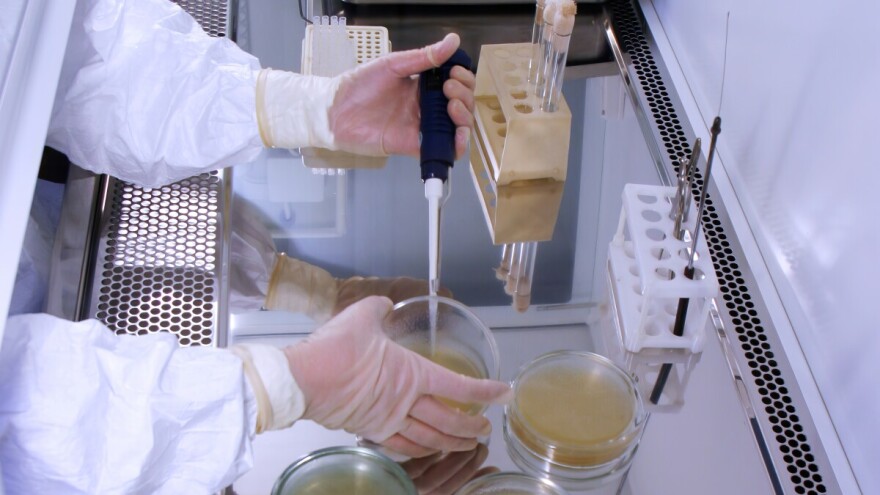
Dvoje kineskih državljana optuženo za agroterorizam - krijumčarili opasan patogen u SAD?

Dvoje kineskih državljana, naučnica Junćing Đian (33), postdoktorantkinja na Univerzitet Mičigen i njen partner Zunjong Liu (34), optuženi su za pokušaj krijumčarenja opasnog gljivičnog patogena u Sjedinjene Američke Države, saopštilo je američko Ministarstvo pravosuđa (DOJ), a prenosi Msn.
Reč je o gljivici Fusarium graminearum, koju naučna literatura prepoznaje kao potencijalno biološko oružje, posebno u kontekstu agroterorizma. Uz potencijalne posledice po zdravlje ljudi, izaziva ozbiljne bolesti useva i može da načini štetu od više milijardi dolara godišnje.
Prema službenom saopštenju Ministarstva pravosuđa, pokušali su da je unesu preko Međunarodnog aerodroma Detroit, a pronađena je u Liuevom ruksaku u plastičnim kesicama umotanim u maramice.
Navode i da je Liu zaposlen na kineskom univerzitetu, gde sprovodi istraživanja na istom patogenu, a da je tokom ispitivanja u početku lagao američke službenike, ali je kasnije priznao da je Fusarium graminearum uneo u SAD preko aerodroma Detroit.
Cilj krijumčarenja, naveli su, bio je nastavak istraživanja u laboratoriji Univerziteta Mičigen, gde je Đian bila zaposlena. Oboje su navodno primali finansijska sredstva kineske vlade za istraživačke projekte.
Ministarstvo pravosuđa dodatno navodi da je u Đianinim elektronskim uređajima pronađena dokumentacija koja upućuje na njeno članstvo i odanost Komunističkoj partiji Kine.
Američke vlasti ovaj slučaj tretiraju kao ozbiljnu pretnju biološkoj sigurnosti, s obzirom na mogućnost da se ovakvi patogeni mogu koristiti za sabotažu poljoprivredne proizvodnje. Istraga je u toku.